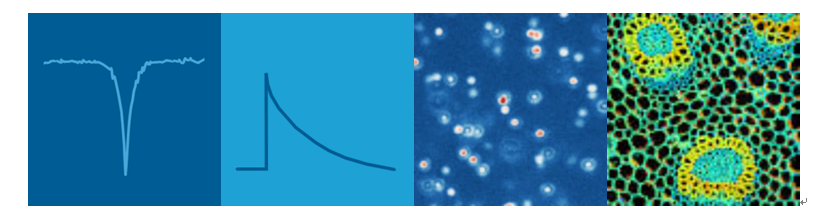
image.png

Swabian Instruments時(shí)間數(shù)字轉(zhuǎn)換器 Time Tagger X 是 Swabian Instruments 時(shí)間數(shù)字轉(zhuǎn)換器系列的旗艦產(chǎn)品,它具有獨(dú)特?cái)?shù)據(jù)處理架構(gòu),實(shí)現(xiàn)了全部通道的2 ps均方根抖動的高速采集性能,將Time Tagger產(chǎn)品族的優(yōu)異性能發(fā)揮到高水準(zhǔn),尤其適用于單光子計(jì)數(shù)時(shí)間相關(guān)測量、時(shí)間間隔計(jì)數(shù)、符合計(jì)數(shù)、頻率穩(wěn)定性分析和數(shù)字協(xié)議分析。Time Tagger應(yīng)用廣泛,可用于包括量子技術(shù)、單分子顯微鏡、熒光相關(guān)光譜、動態(tài)光散射、激光測距、粒子物理和準(zhǔn)確時(shí)間協(xié)議同步測試等諸多領(lǐng)域。
u Time Tagger 產(chǎn)品應(yīng)用特色:時(shí)間相關(guān)單光子計(jì)數(shù)的新標(biāo)準(zhǔn)
Time Tagger 系列為單光子計(jì)數(shù)提供了無窮無盡的功能,您可以毫不費(fèi)力地釋放它們。無論您是使用 Time Taggers 自帶的強(qiáng)大軟件,還是使用 Python、Matlab、LabVIEW 或 C#/C++ 這些編程語言 - 您都可以在幾分鐘內(nèi)啟動并運(yùn)行您的實(shí)驗(yàn)。
主要功能:
? 反聚束效應(yīng)
? 符合計(jì)數(shù)
? 激光掃描顯微鏡
? 多維直方圖
? 支持 SPADs、PMTs、SNSPDs、SiPMs
u Time Tagger讓頻率穩(wěn)定性分析變得簡單
您是否正在尋找多功能頻率計(jì)數(shù)器或連續(xù)時(shí)間間隔分析儀 (CTIA)?您是否執(zhí)行Allan方差、修正Allan方差或Hadamard方差測量?或者您是否 測試秒脈沖信號的同步?Time Tagger 系列讓您比以往更輕松地做到這一點(diǎn)。
主要功能:
? 每秒8E-13水平的Allan方差
? 實(shí)時(shí)ADEV、MDEV、HDEV、相位和頻率 誤差測量
? 同時(shí)多達(dá)18個通道的輸入
? 簡單的秒脈沖信號測試和記錄
? 原始數(shù)據(jù)的實(shí)時(shí)記錄與后處理

u Time Tagger將動態(tài)光散射實(shí)驗(yàn)提升到一個新水平
理想的定時(shí)分辨率的定時(shí)分辨率與眾多探測器上的無限對數(shù)直方圖相結(jié)合,這就是 Time Tagger 的動態(tài)光散射能力。
主要功能:
? 同時(shí)測量多達(dá) 18 個不同的散射角
? 使用高級數(shù)據(jù)過濾工具在運(yùn)行中和后期處理中消除強(qiáng)度峰值
? 使用累積量和 CONTIN 分析計(jì)算粒度分布
? 皮秒級的分辨率

u Time Taggers產(chǎn)品特點(diǎn):
輕松實(shí)現(xiàn)您的研究思路
Time Taggers 強(qiáng)大的軟件引擎為您提供了豐富的數(shù)據(jù)處理功能,相關(guān)性、一維和多維直方圖、多通道符合計(jì)數(shù)等等都可以輕松實(shí)時(shí)運(yùn)行,讓您可以輕松將創(chuàng)新的研究思路變成現(xiàn)實(shí)。
靈活的自定義數(shù)據(jù)采集
Time Tagger 使您可以使用輸入通道的任意組合自定義您的測量,您可以使用一個Time Tagger讀取記錄來自不同硬件的輸入信號,也可以將從一個輸入通道獲取的信號同時(shí)應(yīng)用于不同的測量。
優(yōu)異的時(shí)間分辨
Time Tagger 低至4 ps的均方根時(shí)間抖動和低至2.1 ns的死時(shí)間均遠(yuǎn)遠(yuǎn)優(yōu)于市面同類產(chǎn)品,這可以滿足您創(chuàng)新應(yīng)用的苛刻要求。
高速數(shù)據(jù)傳輸
Time Tagger 高達(dá)每秒7000萬個標(biāo)簽的數(shù)據(jù)傳輸率為縮短測量時(shí)間提供了可能,同時(shí)保證了高速傳輸中的即時(shí)處理能力。
板載事件過濾器
Time Tagger 具有的獨(dú)特板載事件過濾器使您在硬件端即過濾掉與測量無關(guān)的輸入信號而無需通過USB傳輸至軟件端,這有效保證了輸入信號的高速傳輸。
強(qiáng)大的本機(jī)庫
Time Tagger 支持包括python、MATLAB、LabVIEW、C#、C ++和Mathematica在內(nèi)的多種編程語言和架構(gòu),您可以利用我們免費(fèi)的本機(jī)庫和代碼示例,個性化設(shè)計(jì)、操作實(shí)驗(yàn)。
無限網(wǎng)絡(luò)能力
用戶可以使用 Time Tagger 的軟件引擎將實(shí)驗(yàn)中獲得的時(shí)間標(biāo)簽流投射到網(wǎng)絡(luò)中。用戶可以像使用 Time Tagger 硬件一樣通過客戶端啟動虛擬 Time Tagger,并實(shí)現(xiàn)如硬件 Time Tagger 一樣完整的測量和數(shù)據(jù)處理能力。
強(qiáng)大的本機(jī)庫
Time Tagger支持包括python、MATLAB、LabVIEW、C#、C ++和Mathematica在內(nèi)的多種編程語言和架構(gòu),您可以利用我們免費(fèi)的本機(jī)庫和代碼示例,個性化設(shè)計(jì)、操作實(shí)驗(yàn)。
低延遲FPGA輸出
Time Tagger X 引入了低延遲 FPGA 接口,可以實(shí)現(xiàn)每秒高達(dá) 300 M 標(biāo)簽的傳輸帶寬,可將實(shí)驗(yàn)中獲得的時(shí)間標(biāo)簽傳輸?shù)接脩舻?FPGA 中以實(shí)現(xiàn)更復(fù)雜的數(shù)據(jù)處理。使用我們免費(fèi)的 FPGA 參考設(shè)計(jì)立即開始您的 FPGA 項(xiàng)目。
u Time Tagger X產(chǎn)品規(guī)格參數(shù)
產(chǎn)品型號 | Time Tagger X |
計(jì)時(shí)精度 | |
均方根抖動 | 2.0 ps |
半峰寬抖動 | 4.7 ps |
數(shù)字分辨率 | 1 ps |
處理能力 | |
輸入通道 | 4 to 18 |
死區(qū)時(shí)間 | 1.5 ns |
數(shù)據(jù)傳輸率(至計(jì)算機(jī)) | 70 M tags/s |
數(shù)據(jù)傳輸率(FPGA板間) | 300 M tags/s |
猝發(fā)內(nèi)存 | 512 M tags |
最大輸入頻率 | 700 MHz |
輸入信號 | |
輸入阻抗 | 50 Ω / 1 MΩ |
輸入電壓 | -1.5 to 1.5 V |
最大輸入電壓 | -3 to 3 V |
觸發(fā)信號電壓 | -0.75 to 0.75 V |
最小脈沖寬度 | 350 ps |
最小脈沖高度 | 100 mV |
外部時(shí)鐘 | |
頻率 | 10 MHz or 500 MHz |
耦合 | AC, 50 Ω |
振幅 | 0.5 to 4 Vpp |
一般參數(shù) | |
數(shù)據(jù)傳輸接口 | USB 3.0, SFP+ |
尺寸(長 x 寬 x 高) | 380 x 480 x 90 (2U) |
儀器響應(yīng)指標(biāo)
在兩個輸入通道中加載頻率為 1 MHz,幅值為1 Vpp,上升沿1 ns,占空比50%的觸發(fā)信號。兩個通道相關(guān)性測量得到的分布標(biāo)準(zhǔn)差 即代表兩個輸入通道的時(shí)間抖動。每個輸入通道的均方根(RMS)抖動約為σ/√2。 該分布近似為高斯分布,因此每個通道的半高寬(FWHM)抖動約為 2.35σ/√2。
下圖所示為8個輸入通道的儀器響應(yīng)測量中獲得的均方根抖動結(jié)果

uTime Tagger產(chǎn)品應(yīng)用舉例:
利用FPGA開發(fā)板實(shí)現(xiàn)低延遲、高速率數(shù)據(jù)傳輸

Time Tagger X可以和用戶的FPGA板聯(lián)合工作,使用官方提供的SDK,,可以實(shí)現(xiàn)高達(dá)300M tags/s的速率傳輸數(shù)據(jù),可快速反饋回路(光子量子計(jì)算、顯微鏡控制等),可自定義輸出觸發(fā)器,自定義輸出生成任意波形信號輸出,無限的客戶定制功能輸出。